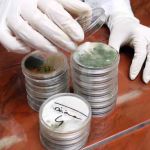
AEI Decon Meth & Mold Remediation

Water Damage Restoration in Washington Avenue, Dumont, New Jersey | Trusted Local Cleanup & Repair Services
- AlabamaArizonaCaliforniaColoradoFloridaGeorgiaKansasLouisianaMassachusettsMississippiMissouriNevadaNew MexicoNorth CarolinaOregonRhode IslandSouth CarolinaTennesseeTexasVirginiaWashingtonWest Virginia
- Atlantic CountyBergen CountyBurlington CountyCamden CountyCape May CountyCumberland CountyEssex CountyGloucester CountyHudson CountyHunterdon CountyMercer CountyMiddlesex CountyMonmouth CountyMorris CountyOcean CountyPassaic CountySalem CountySomerset CountySussex CountyUnion CountyWarren County
- AllendaleBergenfieldBogotaCarlstadtCliffside ParkDumontEast RutherfordEdgewaterElmwood ParkEnglewood CliffsFair LawnFort LeeFranklin LakesGarfieldHackensackHillsdaleLodiMahwahMidland ParkPalisades ParkParamusRamseyRidgefieldRidgewoodRiver EdgeRochelle ParkSaddle BrookSaddle RiverSouth HackensackTeaneckTenaflyWaldwickWestwoodWyckoff
- West Allendale AvenueKilroy RoadSquaw TrailMcKinley AvenueShip AvenueNew Jersey 71South Washington AvenueIndustrial DriveBernards AvenueBerkeley AvenueHamburg TurnpikeHilltop TerraceStar Lake RoadLinden AvenueBoonton AvenueDivision Street3rd StreetWest StreetWest Union AvenueHarbor RoadNew York AvenueSouth Community DriveHarding HighwayValley RoadRavenwood Drive NorthGrand StreetRoosevelt AvenueLincoln AvenuePark AvenueAnderson AvenueClifton BoulevardHolly StreetMain AvenueAtlantic AvenueBelmont AvenueHaddon AvenueCommerce DriveBurlington PikeUnderwood BoulevardBroad StreetMount Pleasant AvenueNorth Morris StreetWashington AvenueWest Shore AvenueCounty Road 613Morris CourtNew Jersey 18Deforest AvenueCentral AvenueMarcy AvenueSpringdale AvenueMadison StreetU.S. 130Windsor CmnsPinebrook RoadBrunswick AvenueCoral StreetJill CourtKilmer RoadLincoln HighwayNational RoadWainwright StreetWest Moss Mill RoadSteelmans LaneWest Parkway DriveAnna StreetBailey AvenueMagnolia AvenueSouth Elmora AvenueUnion StreetMiller AvenueBrookfield AvenueHarlow CrescentSaddle River RoadGardner RoadGlendale LanePassaic AvenueBartles Corner RoadMinneakoning RoadRiver RoadStangl RoadBridge Plaza NorthKelby StreetFranklin AvenueMunsonhurst RoadNestor StreetNew Jersey 23Bannard StreetGinesi DriveThrockmorton StreetArbutus AvenuePalisade AvenueEast High StreetSouth Academy StreetCrescent BoulevardCourt StreetHackensack AvenueLexington AvenueLodi StreetProspect AvenueWashington StreetKings Highway EastSylon BoulevardChurch StreetHamilton AvenueHorizon Center BoulevardQuakerbridge RoadMays Landing RoadSouth White Horse PikeFrontage RoadVan Winkle AvenuePhyllis StreetN/ANorth 6th AvenueOld Camplain RoadBroadwayNorth Broad StreetHarrison StreetTufts TrailAqueduct PlaceNewtons Corner RoadQuabeck AvenueLaurel AvenueOak AvenueCassville RoadCpl Luigi Marciante Junior Memorial DriveHerman RoadNorth County Line RoadWest County Line RoadForsgate DriveObrien StreetNorth 19th StreetSouth 31st StreetFrassetto WayEast Elizabeth AvenueNorth Wood AvenueHolly LaneCardinal DriveConover PlaceIndustrial ParkwaySouth Livingston AvenueWest Mount Pleasant AvenueFarnham AvenueBranchport AvenueEmmons StreetNorwood AvenueWestwood AvenueGlenwild RoadFranklin TurnpikeMyrtle AvenueKimberly CourtPension RoadMonroe AvenueCenter AvenueFreneau AvenueBranch StreetNew Jersey 70High StreetLiberty StreetLincoln BoulevardUnion AvenueKings HighwayTindall RoadGreenwood AvenueNew Jersey 33G StreetRieck AvenueRogers AvenueSherman AvenueAbeel RoadLackawanna PlazaNorth Willow StreetAbbett AvenueGarden StreetHeadquarters PlazaKing StreetMalcolm StreetMount Kemble AvenueSouth StreetWest Park PlaceAshurst LaneCountry LaneLong Bridge DriveNew Jersey 38Peppergrass Drive SouthCommons DriveNew Jersey 66Bayard StreetJules LaneKimm DriveNew Jersey AvenueTilton RoadEast Centre StreetBrook DriveLawrence AvenueEast Edsall BoulevardCinnaminson AvenueWoodland AvenueHowe AvenueAirport HighwayIndustrial RoadState StreetNorth Riverview RoadSouth 4th StreetSouth Main Street10th Street11th StreetEthel RoadSuttons LaneSouth BroadwayNorth AvenueSouth AvenueTerrill RoadBlack Horse PikeCambria AvenueRichmond AvenueAlexander RoadEmmons DriveNassau StreetNorth 11th StreetColonial DriveEast Cherry StreetRegina AvenueWescott DriveNorth Central AvenueFranklin RoadMillbrook AvenueNewman Springs RoadWest Sunset AvenueEdgewater AvenueEdgewater Avenue WestPinewood DriveKinderkamack RoadNorth Gold DriveChestnut StreetPine StreetEast Highland ParkwayEast 9th AvenueEast Clements Bridge RoadNorth Midland AvenueStrathmore TerraceEast Saddle River RoadGrant StreetRaritan StreetEast 2nd StreetPlainfield Avenue78th Street1st StreetLighting WayWindsor DriveWhite Pine CourtGrace Street7th StreetMerion DriveBlue Grass BoulevardEast Main StreetHenry StreetNorth BroadwayLouis StreetHamilton BoulevardRyan StreetGrand AvenueWhitehead AvenueColeman CourtLinda LaneMain StreetBennet LaneInman CourtFlora AvenueChatham RoadMaple StreetCedar LaneOak StreetWilliam PlaceAustin AvenueSylvan Avenue38th StreetBergenline AvenueLehigh AvenueRahway AvenueU.S. 22Wellington AvenueBrentwood DriveEast Landis AvenueSouth Main RoadWest Park AvenueBohnert PlaceCrescent AvenueNew Jersey 138New Jersey 34Wyckoff RoadCounty Road 628County Road 504Newark Pompton TurnpikeTorbet DriveWilliam StreetCounty Road 506Smull AvenueHenley CourtImperial WayJohn F. Kennedy BoulevardExecutive DrivePrinceton Hightstown RoadElm StreetRyan AvenueCarver AvenueRedwood AvenueMantua PikeBraen AvenueLawlins Road
 HomeSquarePro Westchester County4.0 (89 reviews)
HomeSquarePro Westchester County4.0 (89 reviews)78 Washington Ave, Pleasantville, NY 10570, USA
 Taylor Pro Water Damage4.0 (29 reviews)
Taylor Pro Water Damage4.0 (29 reviews)3434 Washington Ave D, Houston, TX 77007, USA
 Roto-Rooter Plumbing & Water Cleanup4.0 (5093 reviews)
Roto-Rooter Plumbing & Water Cleanup4.0 (5093 reviews)2671 Washington Ave, St. Louis, MO 63103, USA
 Rainbow Restoration of Greater Portland5.0 (51 reviews)
Rainbow Restoration of Greater Portland5.0 (51 reviews)2 Washington Ave, Scarborough, ME 04074, USA
 SG Basement Waterproofing Albany NY4.0 (26 reviews)
SG Basement Waterproofing Albany NY4.0 (26 reviews)194 Washington Ave, Albany, NY 12210, USA
 SERVPRO of East Albany, East Greenbush4.0 (28 reviews)
SERVPRO of East Albany, East Greenbush4.0 (28 reviews)130 Washington Ave Suite L, Albany, NY 12210, USA
 Emergency Relief Restoration LLC5.0 (185 reviews)
Emergency Relief Restoration LLC5.0 (185 reviews)62 Washington Ave # 3, Dumont, NJ 07628, USA
 Mold Medics5.0 (678 reviews)
Mold Medics5.0 (678 reviews)811 Washington Ave, Carnegie, PA 15106, USA
 Absolute DKI4.0 (35 reviews)
Absolute DKI4.0 (35 reviews)8100 Washington Ave, Mt Pleasant, WI 53406, USA
 Grit Out5.0 (3 reviews)
Grit Out5.0 (3 reviews)4319 Washington Ave Suite A, New Orleans, LA 70125, USA
 Bordi Restoration2.0 (3 reviews)
Bordi Restoration2.0 (3 reviews)1271 Washington Ave Ste 749, San Leandro, CA 94577, USA
 Fire & Water Damage Recovery4.0 (85 reviews)
Fire & Water Damage Recovery4.0 (85 reviews)2495 Washington Ave, San Leandro, CA 94577, USA
- A-1 Master Service5.0 (3 reviews)
175 Washington Ave, Dumont, NJ 07628, USA
- 911 Restoration of New Jersey4.0 (20 reviews)
320 Washington Ave, Hackensack, NJ 07601, USA
- Apex Restoration4.0 (17 reviews)
1405 Washington Ave, Lincoln Park, MI 48146, USA
Categories
Top Visited Sites
 Rainbow Restoration of Pasadena5.0 (10 reviews)
Rainbow Restoration of Pasadena5.0 (10 reviews) Stanley Steemer4.0 (49 reviews)
Stanley Steemer4.0 (49 reviews) 360 Water Damage5.0 (10 reviews)
360 Water Damage5.0 (10 reviews) BELFOR Property Restoration3.0 (7 reviews)
BELFOR Property Restoration3.0 (7 reviews) AEI Decon Meth & Mold Remediation5.0 (37 reviews)
AEI Decon Meth & Mold Remediation5.0 (37 reviews) Unlimited Fire Restoration4.0 (79 reviews)
Unlimited Fire Restoration4.0 (79 reviews)Top Water Damage Restoration Searches
servpro fort lauderdale southpuroclean of san fernandokustom restorationdry kings restoration of san franciscovalleywide restoration mesa azservpro of santa maria
Trending Damage Repair Guides Posts
 How to Restore Water-Damaged Clothing and Textiles
How to Restore Water-Damaged Clothing and Textiles Tips for Preventing Water Damage During Storms
Tips for Preventing Water Damage During Storms How to Safely Remove Water From Hardwood Floors: Expert Tips
How to Safely Remove Water From Hardwood Floors: Expert Tips How to Prevent Water Damage from Ice Dams in Your Roof
How to Prevent Water Damage from Ice Dams in Your Roof How to Restore Water-Damaged Wooden Furniture
How to Restore Water-Damaged Wooden Furniture How to Dry Out Water-Damaged Carpets Effectively | Step-by-Step Guide
How to Dry Out Water-Damaged Carpets Effectively | Step-by-Step Guide
